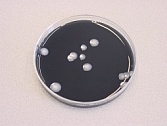

Zorgplicht Waterleidingbesluit:
Alle eigenaren van collectieve drinkwaterinstallaties die n.a.v. genoemde
wijzigingen niet meer onder de verplichting van de voormalige Tijdelijke
regeling vallen, dienen zich thans te onderwerpen aan deze regelgeving. In het kort komt dit er op neer, dat de eigenaar nog steeds aansprakelijk is en verantwoording dient af te leggen voor de kwaliteit van het drinkwater, welke aan derden ter beschikking wordt gesteld.
Toezichthouder: VROM-inspectie



WHBVZ:
Zwembaden vallen onder de Wet Hygiëne en Veiligheid in Baden en Zwemgelegenheden voor het badwater. Het collectieve drinkwatersysteem, voor o.a. de douches, is hier nadrukkelijk in geregeld.
Toezichthouder: De Provincie



Evenementenwet:
Kent regelingen voor grootschalige evenementen als beursen, festiviteiten en
tentoonstellingen.
Toezicht: Gemeente


Model Meetprogramma van het ministerie VROM:
Eigenaren, die het collectieve drinkwatersysteem onttrekken middels grondwaterwinning en/of behandelen met een centraal onthardingsysteem of een andere behandelingsmethodiek, dienen het water op diverse parameters periodiek te laten analyseren.
Toezichthouder: Vrom Inspectie middels waterleidingbedrijf

Intermediair
WCS werkt in nauw overleg met de VROM-inspectie, KIWA, VEWIN en GGD, om voor deze groepen van eigenaren de benodigde risico-analyses en beheersplannen te kunnen verzorgen met het complete vervolgtraject.